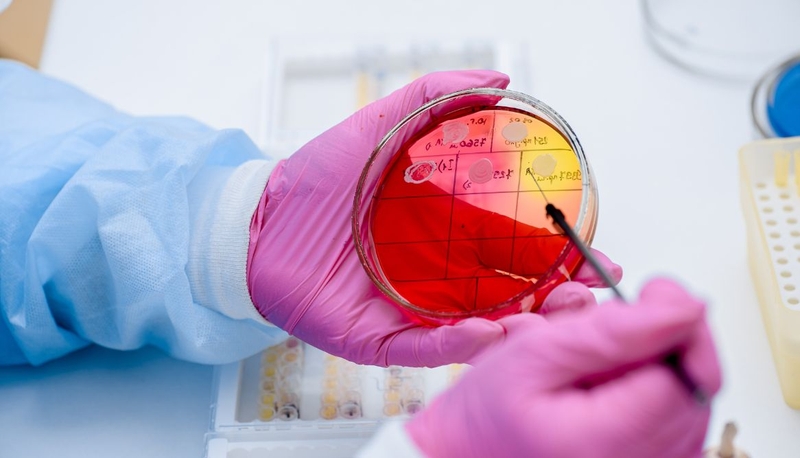
Chi tiết về phác đồ kháng sinh trị viêm phổi do phế cầu 4

Thanh Hương
07/05/2025
Mặc định
Lớn hơn
Viêm phổi do phế cầu khuẩn là một bệnh nhiễm trùng phổi nghiêm trọng, có thể gây ra những biến chứng nguy hiểm nếu không được điều trị kịp thời. Việc sử dụng kháng sinh trị viêm phổi do phế cầu đúng cách giúp kiểm soát bệnh, ngăn ngừa các biến chứng nặng.
Viêm phổi do phế cầu tình trạng nhiễm trùng phổi do vi khuẩn Streptococcus pneumoniae (phế cầu khuẩn) gây ra. Bệnh có thể diễn tiến nhanh và gây nhiều biến chứng nguy hiểm. Kháng sinh là phương pháp điều trị chính, giúp tiêu diệt phế cầu khuẩn và giảm triệu chứng nhanh chóng. Tuy nhiên, việc lựa chọn tuân thủ đúng phác đồ kháng sinh trị viêm phổi do phế cầu là rất quan trọng để đạt được hiệu quả tối ưu và tránh tình trạng kháng thuốc.
Các nguyên tắc sử dụng kháng sinh trong điều trị viêm phổi do phế cầu khuẩn giúp đạt hiệu quả tối ưu, hạn chế biến chứng và phòng ngừa kháng thuốc. Dưới đây là một số nguyên tắc quan trọng khi dùng kháng sinh trị viêm phổi do phế cầu:

Dưới đây là một số nhóm kháng sinh trị viêm phổi do phế cầu được dùng phổ biến:
Kháng sinh nhóm Beta-lactam (penicillin, ampicillin, amoxicillin, cephalosporin) là lựa chọn đầu tay cho viêm phổi do phế cầu khi vi khuẩn còn nhạy cảm. Cephalosporin thế hệ 2 - 3 (cefuroxime, ceftriaxone) được ưu tiên cho ca nặng hoặc bệnh nhân nhập viện. Tuy nhiên, tỷ lệ kháng penicillin ngày càng tăng (đặc biệt ở chủng có MIC ≥4 µg/ml), đòi hỏi tăng liều hoặc chuyển sang kháng sinh khác.
Kháng sinh nhóm Macrolide (azithromycin, clarithromycin) thường kết hợp với beta-lactam để giảm tỷ lệ tử vong ở bệnh nhân viêm phổi nặng. Nghiên cứu gần đây cho thấy việc kết hợp macrolide có thể giúp giảm tỷ lệ tử vong ở bệnh nhân viêm phổi do phế cầu, đặc biệt là đối với các bệnh nhân có nhiễm trùng huyết.
Tetracycline là nhóm kháng sinh phổ rộng. Doxycycline là lựa chọn thay thế khi bệnh nhân dị ứng beta-lactam/macrolide hoặc điều trị ngoại trú. Thuốc ức chế tổng hợp protein của phế cầu, hiệu quả với chủng nhạy cảm (MIC ≤0.25 µg/ml). Tuy nhiên, doxycycline không được khuyến cáo cho trẻ em dưới 8 tuổi (nguy cơ hỏng men răng) và hạn chế dùng ở vùng có tỷ lệ kháng tetracycline cao.

Levofloxacin, moxifloxacin có thể được sử dụng khi điều trị thất bại với beta-lactam hoặc trong trường hợp nghi ngờ kháng đa thuốc, nhưng nên hạn chế sử dụng để tránh kháng thuốc. Những thuốc kháng sinh trị viêm phổi do phế cầu này ức chế enzyme DNA gyrase, hiệu quả với phế cầu kháng penicillin (kể cả chủng MIC ≥4 µg/ml). Tuy nhiên, nên ưu tiên phối hợp với beta-lactam trong ca nặng.
Ngoài các loại trên, còn một số kháng sinh khác cũng được dùng trong điều trị bệnh viêm phổi do phế cầu khuẩn như:
Dưới đây là phác đồ dùng kháng sinh trị viêm phổi do phế cầu theo từng thể bệnh, được xây dựng dựa trên khuyến cáo của CDC, WHO và các nghiên cứu lâm sàng mới nhất:
Bệnh nhân không có dấu hiệu suy hô hấp, huyết áp ổn định (CURB-65 ≤1) được chỉ định:

Bệnh nhân có dấu hiệu suy hô hấp nhẹ, huyết áp không ổn định (CURB-65 = 2) được dùng kháng sinh trị viêm phổi do phế cầu theo phác đồ sau:
Nghiên cứu từ Bệnh viện Nguyễn Tri Phương (2024) cho thấy, phác đồ cephalosporin + macrolide đạt tỷ lệ thành công 85% ở bệnh nhân nhập viện, giảm thời gian nằm viện trung bình 3 ngày so với đơn trị.
Bệnh nhân suy hô hấp nặng, sốc nhiễm khuẩn, hoặc tổn thương đa thùy phổi (CURB-65 ≥3) được điều trị với phác đồ sau:
Trường hợp nghi ngờ đồng nhiễm vi khuẩn Gram âm (Pseudomonas aeruginosa) sẽ được dùng Piperacillin-tazobactam (4,5g mỗi 6 giờ) hoặc meropenem (1g mỗi 8 giờ) kết hợp aminoglycoside (gentamicin 5mg/kg/ngày) hoặc ciprofloxacin (400mg mỗi 12 giờ). Nếu phế cầu nhạy cảm với penicillin (MIC ≤0,06 µg/ml), bác sĩ có thể sẽ chuyển dùng penicillin G để tránh kháng thuốc.
Thời gian điều trị viêm phổi do phế cầu từ 7 - 10 ngày với thể nhẹ, 10 - 14 ngày với thể nặng hoặc biến chứng. Phác đồ trên cần kết hợp với hỗ trợ hô hấp (thở oxy, máy thở), bù dịch và kiểm soát bệnh nền để tối ưu hiệu quả.
Kháng sinh trị viêm phổi do phế cầu là phương pháp điều trị chính với căn bệnh này. Lựa chọn đúng loại kháng sinh và sử dụng đúng liều lượng là yếu tố quan trọng để bệnh nhân phục hồi nhanh chóng và ngăn ngừa các biến chứng. Ngoài ra, chủ động tiêm vắc xin phế cầu là biện pháp hiệu quả nhất để giảm nguy cơ mắc viêm phổi, viêm màng não, viêm tai giữa và nhiều bệnh lý nguy hiểm khác. Nếu muốn tiêm phòng, bạn có thể đến các Trung tâm Tiêm chủng Long Châu trên toàn quốc để được tư vấn cụ thể nhất.